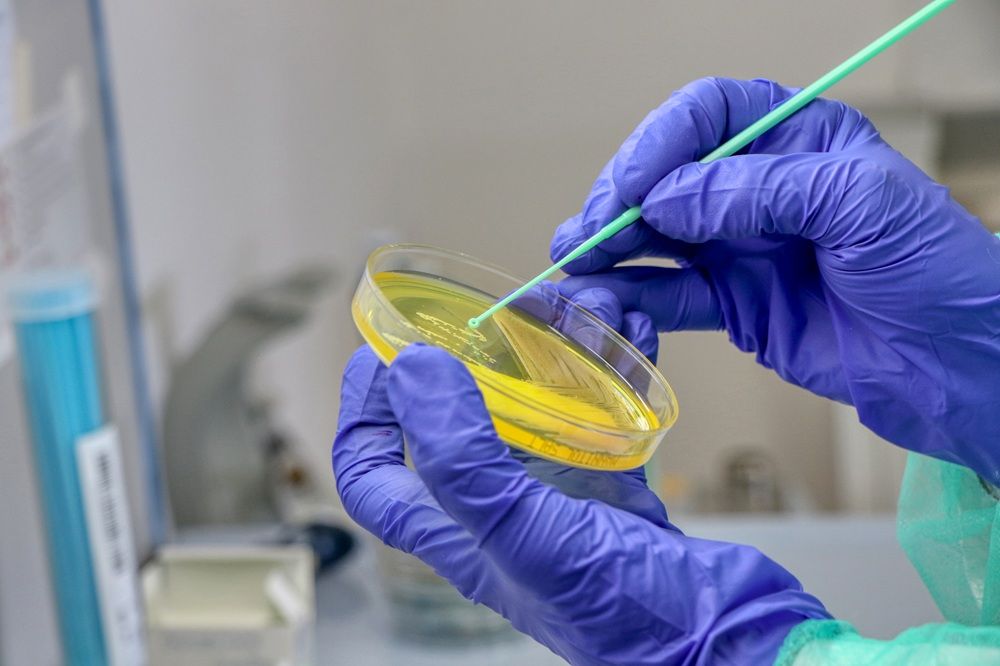

Ce înseamnă screening pentru carbapenemaze
Screeningul pentru carbapenemaze este o investigație microbiologică folosită pentru a identifica purtătorii de bacterii producătoare de carbapenemaze, cel mai frecvent din ordinul Enterobacterales. La SANADOR, pacienții au acces la analize de screening pentru carbapenemaze înainte de internarea în spital, atunci când există indicație pentru această testare, astfel încât procedurile medicale necesare să se desfășoare în siguranță.
Carbapenemazele sunt enzime care inactivează carbapenemele, antibiotice importante în tratamentul infecțiilor severe. Screeningul nu urmărește să stabilească singur un diagnostic de boală, ci să depisteze colonizarea și să sprijine controlul transmiterii în mediul medical.
Prin screening pentru carbapenemaze pot fi identificate din timp bacteriile care produc aceste enzime, chiar și la pacienții care nu prezintă semne și simptome de infecție
În practică, acest screening pentru carbapenemaze este folosit mai ales în spitale sau înaintea internării, la pacienții cu risc. Un rezultat pozitiv arată că bacteria poate fi prezentă pe mucoase sau în tubul digestiv, chiar dacă persoana nu are semne de infecție.
De aceea, testarea are valoare epidemiologică și de siguranță, pentru alegerea măsurilor corecte de prevenire a răspândirii.
-
La SANADOR beneficiezi de analize și investigații necesare pentru un diagnostic rapid și corect. Programează-te!



